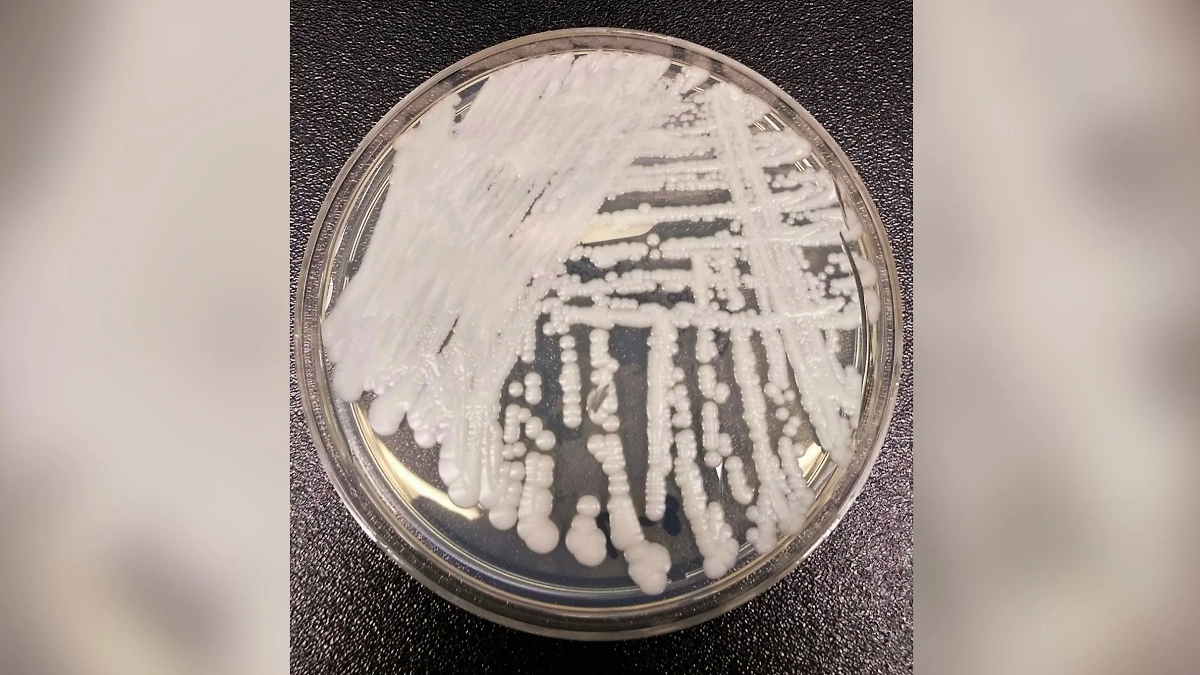
Штамм Candida auris. Фото © Wikipedia / Shawn Lockhart

Почему открытый микологами паук-зомби озадачил учёное сообщество
Оглавление
Одни учёные считают, что человечество стоит на пороге «грибкового» зомби-апокалипсиса, а другие верят, что грибы нас спасут.

Грибок кандида аурис (Candida auris) оказался смертельным для ослабленных людей. Обложка © Shutterstock AI
В Ирландии нашли паука-зомби
Учёные-микологи не на шутку встревожены. В феврале 2025 года на потолке старого порохового склада замка Эспи в ирландском графстве Даун съёмочной группой BBC, снимавшей сериал «Зимний дозор», был обнаружен мёртвый паук, заросший грибком. Участники съёмок осторожно сняли паука с потолка. Очевидно, они вспомнили сюжет сериала «Последние из нас» (Last of Us) о конце света, вызванном грибком, который превращал людей в зомби. Сотрудники BBC отправили паука микологам в Институт биоразнообразия Вестердейка в голландском городе Утрехте, где команда учёных под руководством Гарри Эванса изучила образец, а заодно и исследовала системы пещер, расположенных в Ирландии. Результатом исследований стало открытие сразу двух новых зомби-грибков.

Грибки инфицируют пауков-кругопрядов и вызывают изменения в их поведении. Фото © new-science.ru
Учёные назвали их Gibellula albolanata и Gibellula aranicida и сообщили об открытии в научном журнале Ingenta Connect. Оказалось, что эти грибки инфицируют пауков-кругопрядов и вызывают изменения в их поведении. Это происходит аналогично тому, как ведут себя муравьи-зомби, заражённые грибком кордицепсом. Вместо того чтобы плести сети и сидеть в засаде, пауки выползают на потолки, где ощущается поток воздуха, и там умирают. Поразивший их грибок выпускает споры и распространяется, заражая большую площадь.
«Мы пришли к выводу, что инфицированные пауки демонстрируют изменения в поведении, аналогичные тем, которые наблюдаются у муравьёв-зомби», — сказал Гарри Эванс.
Мёртвые невесты и жуткие гусеницы. Грибки любят насекомых
Собственно, первая волна тревоги в обществе была вызвана именно грибком кордицепсом однобоким. Многих напугал тот факт, что заражённый муравей-древоточец, нервную систему которого постепенно поедает грибок, в последние минуты жизни, словно зомби, поднимается на ветки над муравейником и умирает, застывая. А грибок кордицепс выпускает из мёртвого насекомого споры, которые «засевают» муравейник, заражая целые муравьиные колонии.

Кордицепс. Летом — гриб, зимой — насекомое. Фото © Shutterstock / FOTODOM / w583254846
Микологи, конечно, знали об этом феномене. Как знали и том, что грибок кордицепс не одинок в своих жутких деяниях. Например, дикорастущий и очень дорогой тибетский гриб кордицепс китайский (Cordyceps sinensis) поражает бабочек Hepialus armoricanus. Он проникает в яйцеклад, прикрепляется к яйцам и в конце концов оказывается внутри гусениц, где и развивается, прорастая наружу через глазницы. В Тибете кордицепс называют «летом — трава, зимой — насекомое».
А грибок энтомофтора (Entomophthora muscae) поражает самок мух. Насекомые умирают от него в интересной позе — выставив брюшко и расправив крылышки, что в мушином мире является предложением к спариванию. Более того, коварный грибок ещё и особые феромоны распыляет для привлечения мух-самцов. Те, ничего не подозревая, прилетают к мёртвой невесте и улетают уже заражёнными.

Кордицепс начинает своё плодоношение от осы. Фото © Wikipedia / Erich G
Грибные атаки на людей
Но это всё насекомые, а что же с людьми? А люди тоже переживают атаки грибковых инфекций. Собственно, первая атака микроскопических случилась в 1980-х годах, когда в США от грибковых инфекций стали умирать больные СПИДом.
— Пациенты умирали не от ВИЧ-инфекции, поражающей иммунную систему. ВИЧ просто делал их восприимчивыми к другим инфекциям, в том числе к грибковым. Это был первый в истории человечества масштабный грибковый кризис, — рассказывает профессор молекулярной микробиологии и иммунологии Университета Джонса Хопкинса Артуро Касадевалл.
Штамм Candida auris. Фото © Wikipedia / Shawn Lockhart
Вторая атака идёт прямо сейчас. Она началась в 2007 году, когда в Японии учёные впервые обнаружили в теле престарелой пациентки совершенно новый грибок, убивавший её. Его назвали кандида аурис (Candida auris), и он оказался смертельным для ослабленных людей. Особую тревогу внушает тот факт, что он устойчив к противогрибковым средствам и антибиотикам. Пока учёные разрабатывают лекарства для борьбы с ним, грибок распространяется по миру. Он уже обнаружен в Африке, Индии, Южной Америке, Бельгии, Пакистане, США, Британии, Таиланде, ОАЭ и других странах. Его уже объявили опасной внутрибольничной инфекцией. Есть он и в России. Передаётся через кровь, слюну и другие жидкости, в том числе половым путём. Вызывает пневмонию, воспаление среднего уха, артрит, гломерулонефрит и сепсис, убивает 33% заболевших и очень сложно диагностируется.
Смертельные грибки — результат глобального потепления
У учёных есть повод для всеобщего «аларма». Они считают, что кандида аурис — лишь первая ласточка, первая «пуля», пробившая броню главной защиты человеческого организма от грибков — высокой температуры тела. Всё же большинство грибков предпочитают заселять более прохладных носителей: насекомых, крабов или земноводных. Дрожжевые грибки, лишай или грибки на ногтях не в счёт — они неприятны, но не убивают людей. А у человечества всегда была температура тела, неприятная для грибковой инфекции. Возможно, она появилась именно вследствие формирования защитных механизмов от грибковых инфекций. И вот стены крепости пали.

Фото © Shutterstock / FOTODOM / Andrey_Popov
Виной всему считают глобальное потепление. Царство грибов небезобидно. Внутри него постоянно идёт жёсткая конкуренция, грибки приспосабливаются, чтобы выжить. Возможно, общее потепление климата и летняя жара поспособствовали тому, что один из них теперь может прекрасно себя чувствовать и развиваться внутри человеческого организма. Кроме того, человеческое тело за последнее столетие стало не намного холоднее. Если раньше внутренняя температура составляла минимум 37 °C, то теперь она опустилась до 36,6 °C (не путать с температурой под мышкой). Это значит, что следом за одним грибком появятся и другие грибки-убийцы.
«Это медицинская загадка, — комментирует появление кандиды аурис Артуро Касадевалл. — Это первый грибок, который прорвался через наши тепловые барьеры, и, вероятно, это первый пример грибкового заболевания, возникшего из-за изменения климата».
В 2020 году появился ещё один грибок, способный жить в человеке. Это Cryptococcus deneoformans. Он приобрёл эту способность из-за мутации.
Возможен ли «грибной» зомби-апокалипсис?
Несмотря на то что все открытые грибки, заставляющие насекомых вести себя как зомби, не способны заразить человека, западные учёные настороже. Они считают, что подобный сценарий маловероятен, но всё же возможен. Уже сейчас миллионы людей страдают от грибков, а полтора миллиона каждый год от них умирает. Дополнительными факторами, влияющими на способность грибков заражать людей, является старение населения, плохая экология, несбалансированное питание, ожирение и пандемии вроде ковида.

Кадр из фильма «Одни из нас», режиссёр Крейг Мейзин и др. / Kinopoisk
— Грибковые инфекции становятся серьёзной проблемой, — считает американский миколог Мэтью Кассон (Университет Западной Вирджинии). — Думаю, ситуация будет ухудшаться. Чем раньше мы это поймём, тем раньше мы сможем придумать решения, которые помогут всем.
Грибы против грибков
У российских микологов, как обычно, своё мнение насчёт «грибкового апокалипсиса». Например, кандидат биологических наук, миколог и блогер Ирина Филиппова считает, что нужно держать ухо востро, но не стоит сбрасывать со счетов умение человека защищаться.
— Чтобы бороться с грибком, нужно знать его природу. А он уязвим — не выносит кислоты и щёлочи. Поэтому на Руси издревле ополаскивали голову слабым раствором уксуса, мылись щелочным и дегтярным мылом. В XX веке наружно стали применять янтарную и салициловую кислоты, — заявила Филиппова.
По её словам, важно помнить, что грибы грибам антагонисты. Патогенные грибки боятся базидиальных (высших) грибов. Поэтому против них применяется чага, губка лиственничная, кордицепс, содержащий сильную кордицепиновую кислоту, лисички — чёрная и жёлтая. Они осуществляют серьёзную противогрибковую защиту организма человека. Если наука и придумает новые препараты для борьбы с грибковыми инфекциями, то, скорее всего, они будут на основе веществ, которые содержатся в высших грибах. А это — целая аптека. Недаром учёные говорят: царство грибов. Тот же дикорастущий гриб кордицепс, поражающий гусениц, — лечит у людей туберкулёз, саркоидоз, стимулирует иммунитет и облегчает состояние больных деменцией и болезнью Паркинсона. Что же касается грибковой пандемии, то об опасности люди уже предупреждены. А значит, будут предусмотрительнее.


